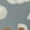
2 Black-1, variant on White Popcorn Pattern Adult Middle Tube Socks Breathable Sock Non-Pilling,Contrasting Color Design

Popcorn Socks(400)
Uses item details. Price when purchased online
Funny Popcorn Socks Box for Men Dad Women Teen Boys - Funny Gifts Novelty Crazy Silly Cool Socks-Easter Fathers Valentines Birthday Gag Christmas Gifts Stocking Stuffers From $14.99

Sponsored
From$1499
Cantustime
Funny Popcorn Socks Box for Men Dad Women Teen Boys - Funny Gifts Novelty Crazy Silly Cool Socks-Easter Fathers Valentines Birthday Gag Christmas Gifts Stocking Stuffers944.7 out of 5 Stars. 94 reviews
OoohYeah Novelty Mens Crew Socks, Funny Fashion Food Socks, Box O' Popcorn From $9.85

Sponsored
From$985
Oooh Yeah
OoohYeah Novelty Mens Crew Socks, Funny Fashion Food Socks, Box O' Popcorn25 out of 5 Stars. 2 reviews
Womens Novelty Knee High Socks | Popcorn Mini-Buckets Themed Fashion Novelty Socks | 2 Pairs Included $12.95

$1295
current price $12.95foozys
Womens Novelty Knee High Socks | Popcorn Mini-Buckets Themed Fashion Novelty Socks | 2 Pairs IncludedPopcorn Socks Over the Calf Length (White/Scarlet, Medium)

3 options
Available in additional 3 optionsMadSportsStuff
Popcorn Socks Over the Calf Length (White/Scarlet, Medium)- Popcorn Fashion Socks $12.95

$1295
current price $12.95Function
- Popcorn Fashion SocksBox of Popcorn Socks, One Size $12.99

$1299
current price $12.99For Bare Feet
Box of Popcorn Socks, One SizeReduced price Vibrant Popcorn Design Socks - 2 Pairs of Unisex Trendy Socks with Bold ' POPCORN ' & ' LOVE ' Print Perfect for All Seasons Was $18.60

Jane Yi
Vibrant Popcorn Design Socks - 2 Pairs of Unisex Trendy Socks with Bold ' POPCORN ' & ' LOVE ' Print Perfect for All SeasonsReduced price Four Seasons Universal Socks - 2 Pairs of Trendy Unisex Socks with Fun Popcorn Design Black & Red Stripes Bold ' POPCORN ' Print Was $18.60

Jane Yi
Four Seasons Universal Socks - 2 Pairs of Trendy Unisex Socks with Fun Popcorn Design Black & Red Stripes Bold ' POPCORN ' PrintCute Popcorn Funny Silky Novelty Funky Long Knee High Socks Soft 3D Print Cosplay Crazy Stockings for Men Women $16.99

$1699
current price $16.99Kdxio
Cute Popcorn Funny Silky Novelty Funky Long Knee High Socks Soft 3D Print Cosplay Crazy Stockings for Men WomenCompany - Popcorn - S/M Youth Cotton Blend Crew Socks

2 options
Available in additional 2 optionsPavilion Gift
Company - Popcorn - S/M Youth Cotton Blend Crew SocksWhite Popcorn Print Contrast Color Stockings, Elastic Sports Socks Warm Socks Clothing Accessories, Adult Unisex

Gukieu
White Popcorn Print Contrast Color Stockings, Elastic Sports Socks Warm Socks Clothing Accessories, Adult UnisexPopcorn Bamboo Blend Crew Socks - Mens - Male

MeMoi
Popcorn Bamboo Blend Crew Socks - Mens - MaleReduced price Four Seasons Universal Socks - 2 Pairs Unisex Trendy Socks with Vibrant Popcorn Design Bold ' POPCORN ' & ' LOVE ' Print Fun & Colorful Was $18.60

Jane Yi
Four Seasons Universal Socks - 2 Pairs Unisex Trendy Socks with Vibrant Popcorn Design Bold ' POPCORN ' & ' LOVE ' Print Fun & ColorfulReduced price Four Seasons Universal Socks - 2 Pairs of Unisex Trendy Socks with Vibrant Popcorn Cup and Star Pattern Perfect for Fun Style Was $18.60

Jane Yi
Four Seasons Universal Socks - 2 Pairs of Unisex Trendy Socks with Vibrant Popcorn Cup and Star Pattern Perfect for Fun StyleI Am A Fan Popcorn Print Calf Socks Seamless Toe, Knee High Long Socks, Sports Socks Trouser Socks for Women and Men-One Size $16.99

$1699
current price $16.99Xecao
I Am A Fan Popcorn Print Calf Socks Seamless Toe, Knee High Long Socks, Sports Socks Trouser Socks for Women and Men-One SizeCute Popcorn Print Contrast Color Stockings, Elastic Sports Socks Warm Socks Clothing Accessories, Adult Unisex

Gukieu
Cute Popcorn Print Contrast Color Stockings, Elastic Sports Socks Warm Socks Clothing Accessories, Adult UnisexBox O' Popcorn One Size Fits Most Red Ladies Crew Socks $15.00

$1500
current price $15.00Oooh Yeah
Box O' Popcorn One Size Fits Most Red Ladies Crew Socks15 out of 5 Stars. 1 reviews
Reduced price Four Seasons Universal Socks (2 Pairs) - Unisex Trendy Mixed Color Socks with Vibrant Popcorn Cup and Film Strip Design Was $18.60

Jane Yi
Four Seasons Universal Socks (2 Pairs) - Unisex Trendy Mixed Color Socks with Vibrant Popcorn Cup and Film Strip DesignReduced price Four Seasons Universal Socks - 2 Pairs of Unisex Trendy Socks with Playful Red & White Stripes and Fun Popcorn Design Was $18.60

Jane Yi
Four Seasons Universal Socks - 2 Pairs of Unisex Trendy Socks with Playful Red & White Stripes and Fun Popcorn DesignI Am A Fan Popcorn print Women's Men's Novelty 20in Crew Socks Cotton Socks Knee High Socks for Walking,Running,Nurses,Pregnancy-One Size $16.99

$1699
current price $16.99Rateoe
I Am A Fan Popcorn print Women's Men's Novelty 20in Crew Socks Cotton Socks Knee High Socks for Walking,Running,Nurses,Pregnancy-One SizeKnee High Socks for Women Men Athletic - Cute Popcorn No.1001 Thigh-High Black Sole Comfort Breathable Long Socks for Casual Travel Running $14.99

$1499
current price $14.99ZHBwal
Knee High Socks for Women Men Athletic - Cute Popcorn No.1001 Thigh-High Black Sole Comfort Breathable Long Socks for Casual Travel RunningWhite Popcorn Print Crew Socks for Men and Women, Men's Soft Moisture-wicking Sock

Xecao
White Popcorn Print Crew Socks for Men and Women, Men's Soft Moisture-wicking SockPopcorn 6 in. Crew Socks - Small & Medium $28.14

$2814
current price $28.14FashionFirst
Popcorn 6 in. Crew Socks - Small & MediumSmall/Medium Novelty Crew Socks | Movie Popcorn Cute, Fun & Makes a Great Gift! | 2 Pair (Black & Pink) | Womens Shoe Size 4-10 $12.95

$1295
current price $12.95foozys
Small/Medium Novelty Crew Socks | Movie Popcorn Cute, Fun & Makes a Great Gift! | 2 Pair (Black & Pink) | Womens Shoe Size 4-1015 out of 5 Stars. 1 reviews
Reduced price Four Seasons Universal Socks - 2 Pairs of Unisex Trendy Socks with Fun Popcorn Design Red & White Stripes Perfect for Lovers Was $18.60

Jane Yi
Four Seasons Universal Socks - 2 Pairs of Unisex Trendy Socks with Fun Popcorn Design Red & White Stripes Perfect for LoversWhite Popcorn Funny Silky Novelty Funky Long Knee High Socks Soft 3D Print Cosplay Crazy Stockings for Men Women $16.99

$1699
current price $16.99Kdxio
White Popcorn Funny Silky Novelty Funky Long Knee High Socks Soft 3D Print Cosplay Crazy Stockings for Men WomenWomen's Whats Poppin Socks Funny Sarcastic Popcorn Graphic Novelty Footwear $9.99 Was $14.99

Now$999
current price Now $9.99, Was $14.99$14.99
Crazy Dog T-Shirts
Women's Whats Poppin Socks Funny Sarcastic Popcorn Graphic Novelty Footwear